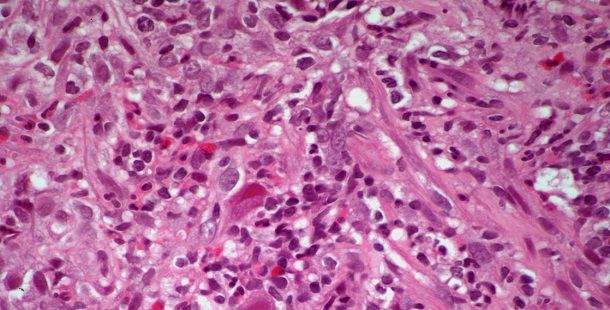
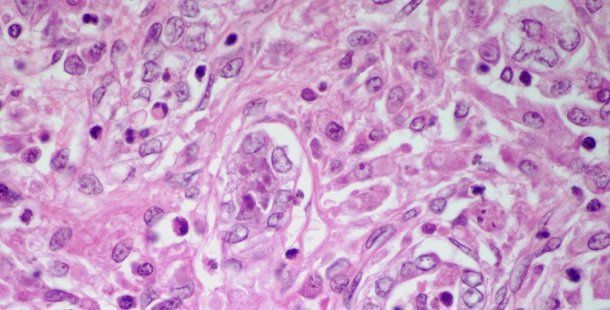

A 37-year-old man presents with a mass in the abdominal area. What is your diagnosis?

Your AI-Trained Oncology Knowledge Connection!


A 58-year-old man presents with a tonsilar mass. After further evaluation, a biopsy is performed. What is your diagnosis?

A 35-year-old man presents with a mass in the right arm. What is your diagnosis?

A 19-year-old man presents with a mass in the right neck. What is your diagnosis?

A 27-year-old man presents with a mass in the right testicle. A biopsy is performed. What is your diagnosis?

A 47-year-old man presents with a mass in the right thigh. A biopsy is performed. What is your diagnosis?

A 63-year-old man presents with a mass in the left kidney. After further evaluation, a biopsy is performed. What is your diagnosis?

A 39-year-old woman presents with dyspnea and cough. A bronchial mass in found. What is your diagnosis?

A 51-year-old man presents with a lung mass. What is your diagnosis?

A 46-year-old woman presents with cough and dyspnea. A bronchial tumor is found and a biopsy is performed. What is your diagnosis?

A 13-year-old boy presents with loss of vision in his right eye and is described as having a pink eye. What is your diagnosis?

A 48-year-old man presents with chest pain. Imaging shows the presence of a chest wall mass. What is your diagnosis?

A 58-year-old man presents with a mass in the right side of the neck. What is your diagnosis?

A 17-year-old boy presents with respiratory difficulty. A mass in the upper respiratory tract is identified. What is your diagnosis?

A 35-year-old woman presents with chest pain. Imaging shows a large anterior mediastinal mass. What is your diagnosis?
%2520gastritis%2520(CM).JPG?w=350&fit=crop&auto=format)
A 35-year-old woman presents with gastric pain. After further analysis, a biopsy is performed. What is your diagnosis?

A 30-year-old man who recently underwent induction chemotherapy for bone marrow transplant is admitted with neutropenia and right lower-quadrant abdominal pain. What is your diagnosis?
.JPG?w=350&fit=crop&auto=format)
A breast biopsy is performed on a 45-year-old woman with microcalcifications detected from a mammogram. What is your diagnosis?
.JPG?w=350&fit=crop&auto=format)
A 61-year-old woman currently being treated for endometrial adenocarcinoma is in need of a liver biopsy. What is your diagnosis?
.JPG?w=350&fit=crop&auto=format)
A 62-year-old man presents with anemia and fever. A renal mass is detected and a biopsy is performed. What is your diagnosis?